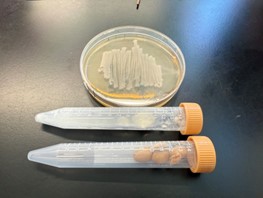

石川県立大学(馬場保徳准教授,河井重幸教授)と富山大学(森脇真希助教)は,公益財団法人発酵研究所の助成を受け,2022年度より微生物研究の楽しさを伝える一般向けセミナーを開催しています。本年度も,「微生物ってなんだろう?顕微鏡で見てみよう!そして微生物で絵を描こう!」をサイエンスヒルズこまつ(石川県小松市)で開催しました。参加者はパン酵母・ヨーグルトの乳酸菌・納豆菌の顕微鏡観察をしたのち,微生物(パン酵母)を絵の具に見立てて,アニメキャラクターやウサギなどを寒天培地に描いてくれました。微生物実験に幼い頃から触れることで,北陸地域における微生物研究の裾野が広がることを期待しています。
- 石川県立大学について
- 石川県立大学について
- 石川県立大学について:TOP
- 大学案内
- 大学概要/各種データ
- 広報・刊行物
- お問い合せ一覧
- 見学申込の受付
- 教職員公募
- 周年記念事業
- 周年記念事業
- 周年記念事業:TOP
- 10周年記念事業
- 20周年記念事業
- 学部・学科
- 大学院
- キャンパスライフ
- キャンパスライフ
- キャンパスライフ:TOP
- 授業料・入学金・奨学金
- 各種手続き
- 学生生活支援・学生相談
- キャンパスカレンダー
- 図書・情報センター
- 図書・情報センター
- 図書・情報センター:TOP
- ご利用案内
- 資料検索用リンク集
- 大学周辺案内
- 学園祭(響緑祭)
- 学園祭(響緑祭)
- 学園祭(響緑祭):TOP
- 過去の響緑祭
- 課外活動
- 就職・進学
- 就職・進学
- 就職・進学:TOP
- キャリアセンター・就職支援室
- 主な進路
- 卒業生の進路状況
- 卒業生の進路状況
- 卒業生の進路状況:TOP
- 過去の卒業生の進路状況
- 修了生の進路状況
- 修了生の進路状況
- 修了生の進路状況:TOP
- 過去の修了生の進路状況
- 資格
- 卒業生インタビュー
- 研究・地域・社会貢献
- 研究・地域・社会貢献
- 研究・地域・社会貢献:TOP
- 産学官連携学術交流センター
- 産学官連携学術交流センター
- 産学官連携学術交流センター:TOP
- 産学官ネットワークナウ
- 産学官連携の成果
- 研究シーズ集
- 教員・研究者情報
- 大学年報
- 石川県立大学×SDGs
- 研究上の倫理・安全
- 出前講座・模擬授業
- 科目等履修生・聴講生
- 公開セミナー
- 特色ある施設
- 特色ある施設
- 特色ある施設:TOP
- 附属農場
- 生物資源工学研究所
- 入試情報
- 入試情報
- 入試情報:TOP
- 学部入試
- 学部:過去問題請求
- 大学院入試
- 大学院:過去問題請求(準備中)
- オープンキャンパス・進学相談会
- オープンキャンパス・進学相談会
- オープンキャンパス・進学相談会:TOP
- 進学相談会参加情報
- 今年度の日程
- 過去のオープンキャンパス
- 入試に関するお問い合せ
- 入学資料請求
- 入試に関するQ&A
- 入試に関するQ&A
- 入試に関するQ&A:TOP
- 入試関連リンク